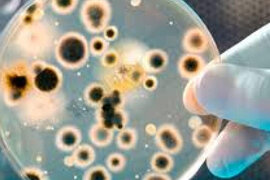
.

Xəbərlər

Koronavirusun yeni bəlası - Antitellər orqanizmə hücum edə bilər
Koronavirusdan sağalanlar ümidlə antikorlar - antitellərin yaranmasını gözləyir, arzulayır və bunun üçün xüsusi analizlər verirlər. Antitellər artıq insanın koronavirus keçirdiyini və orqanizmdə virusu tanıyan immun cavabı

Özəl şirkətlər də ölkəyə koronavirus vaksini gətirsin – TƏKLİF
Azərbaycanda vaksinasiya zamanı alternativ yollardan da istifadə etməliyik. bildirir ki, bunu Trend-ə Milli Məclisin Əmək və sosial siyasət komitəsinin sədri Musa Quliyev deyib. Deputat bildirib ki, dövlətin gətirəcəyi v

İmmunitet nədir? – İmmuniteti artırmaq üçün VASİTƏLƏR
tanınmış fitoterapevt Fizuli Hüseynovun məqaləsini təqdim edir. İmmunitet nədir sualına ilk cavab "orqanizmin xəstəliklərə qarşı müqavimət gücü" olur. Bəs necə etmək lazımdır ki, orqanizm xəstəliklərə az məruz qalsı

Parça maskalar virusdan qorumur?
Parça maskaların heç bir qoruyuculuğu yoxdur. Ümumdünya Səhiyyə Təşkilatının (ÜST) konsultantı, Türkiyənin Hacettepe Universiteti xəstəxanasının azərbaycanlı həkimi Turanə Rəsulova deyib. e- -a istinadən bildirir ki, onu

Bişmiş sarımsağın faydaları: Hansı orqanlara necə təsir edir?
Sarımsaq mətbəxlərin əvəzolunmaz məhsuludur. Çünki onun çoxsaylı faydalarını əksəriyyət bilir. Təbii dərman sayılan sarımsaq ilboyu geniş istifadə olunur. Sarımsaq ən çox çiy halda yeyilir və müxtəlif qidaların - salatlar

Dezinfeksiya necə aparılmalıdır, nələr orqanizmə ziyan vura bilər?
Dezinfeksiya edilən qapalı məkanda dezinfeksiyanı aparanlardan savayı digər şəxslərin olmasına yol verilmir. Məqsəd, qapalı məkanlarda aparılan dezinfeksiya zamanı dezinfeksiyaedici vasitələrin tərkibində olan aktiv maddələri

Uşaqların saçı nədən tökülə bilər?
Böyüklər kimi uşaqlarda da saç tökülməsi olur. Bu, bir çox hallarda normal proses olsa da, bəzən hansısa xəstəlik nəticəsində baş verir. Saç tökülməsi həm saçın, dərinin problemi, həm də hansısa xəstəliyin əlaməti də ol

Aspirin virusdan qorumur, amma COVID-ə yoluxanlarda... - Həkim RƏYİ
Son zamanlar koronavirus müalicəsində ən çox adı hallanan dərmanlardan biri də Aspirindir. Bir çoxları Aspirini koronavirusdan qoruyucu olaraq da qəbul edir. Mütəxəssislər isə onun virusdan qorumaq kimi özəlliyinin olmadığın

Təmizlik vacibdir, sterillik ziyanlıdır – Tanınmış pediatrdan XƏBƏRDARLIQ
Uşağın immun sistemi ilk illərdə çox fəal şəkildə formalaşır. Ətraf mühitin, qidalanmanın və s. amillərin burada çox böyük rolu var. Tanınmış ukraynalı pediatr Yevgeniy Komarovskiy bildirir ki, uşaq təmiz şəraitdə yaşamalıdır

Viruslara qarşı çay resepti
Zeytun yarpağı virus profilaktikasında istifadə edilsə, yaxşı olar. İstifadə etdiyim çayların tərkibində zeytun yarpağı 3-4 ədəd də olsa, olmalıdır. Bunu həkim-fitoterapevt Elnur Eldaroğlu açıqlayıb. O, viruslara qarşı tərkibind

Tromba, xərçəngə, iltihaba, viruslara və bir çox başqa xəstəliyə təsir edən ədviyyat
Gündəlik olaraq mətbəxdə ən çox istifadə etdiyimiz faydalı məhsullardan biri də sarıkökdür. Sarıkök qədim zamanlardan dövrümüzə qədər yeməklərin hazırlanmasında əvəzolunmaz ədviyyat sayılıb. Xalq təbabətində də sarıkökü

Uşaqlarda görmə zəifliyinin əsas səbəbi- Tənbəl göz nədir?
Göz problemləririndən biri də "tənbəl göz"dür. Tibbi dildə Abliopiya adlandırılan bu problem ən çox uşaqlarda aşkarlanır. Daha doğrusu, tənbəl göz problemi uşaqlıq, körpəlik dövründən başlayaraq inkişaf edir. Uşaqlard

Professor: "1,5-2 metr deyil, imkan olduqca daha çox məsafə saxlamaq məsləhətdir"
"Virusun yeni ştammında müəyyən dəyişikliklər ortaya çıxacaq. Yeni virus ştammı sayəsində xəstəliyin klinikası da fərqli gedə, immun sistemimiz bunlara fərqli cavab verə bilər. Bunların heç biri indi bəlli deyil, amm

Çox üşümək, soyuğa qarşı həssaslıq xəstəlikdir?
Soyuq havada, qış mövsümündə bir çox insan soyuğa çox həssasdır və çox isti paltarlarda belə üşüyürlər. Bunun xəstəlik olduğu düşünülür. Bəziləri bunun qanazlığı, bəziləri vitamin çatışmazlığı, bəziləri isə daxili orqanların

COVID-ə yoluxanlar və peyvənd olunanlarda qoruyucu immunitet nə qədər davam edir?
COVID-19-a yoluxub sağalanlarda immunitet - qoruyuculuq düşünüldüyündən daha uzun müddət davam edir. Koronavirus infeksiyası keçirmiş insanlarda yaranan immunitet ən azı səkkiz ay ərzində yenidən yoluxmadan qoruyur. e- -

İnfeksionist: "Qızdırma antibiotik üçün göstəriş deyil, ilk həftədə sadəcə, maye və vitaminlə müalicə olmalıdır"
Vaksinasiya pandemiyanı bitirməyin ən optimal yollarından biridir. Tarixə nəzər salsaq, pandemiyalar üç yoldan biri ilə sona çatıb: kollektiv immunitetin əmələ gəlməsi, vaksinasiyanın kütləvi tətbiqi, virusun özü-özünü öldürəcə

Kartof nə zaman sağlamlığa təhlükə yaradır? Məhsulun keyfiyyətinə mənfi təsir edən amillər
Gün işığı və istilik kartofun tərkibində solanin maddəsinin yaranmasına şərait yaradır. Solanin artıq miqdarda qəbul edildikdə zəhərlənmə, mədə bulantısı, qusma, boğazda yanma, baş ağrısı və baş dönməsi yaradır. Buna gör

Koronavirus zamanı bu simptom ölümün riskini 44% artırır
Koronavirusun ən yayılmış simptomu yüksək qızdırmadır. Lakin bəzən koronavirus xəstəsində qızıdırma nəinki qalxmır, əksinə kəskin düşür. Mütəxəssislər bildirirlər ki, bu çox təhlükəli simptomdur. Həkimlərin müşahidələrin
Yeni nəsil antibiotiklər kəşf olunub: İndiki dərmanlara davamlı supermikrobları zərərsizlədirə bilir
Supermikroblara qalib gəlməyə ikiqat fəaliyyətli-yeni nəsil antibiotiklər kömək edəcək. Bütün məlum antibiotiklərə davamlı bakteriyaları (supermikrobları) öldürürən və həm də immun sistemini onlara qarşı mübarizə aparmağ

Koronavirusa qarşı peyvəndləmə ilə bağlı VACİB MƏQAMLAR – hazırlıq, əks-göstərişlər...
Yanvarda Azərbaycanda koronavirusa qarşı peyvəndlənmə başlaya bilər. Peyvənd insanın orqaniminə və xüsusilə də immun sisteminə çox ciddi "müdaxilə"dir. Bu səbəbdən peyvəndə gedən insan bəzi vacib qaydaları bilməlidi

Koronavirusu bu formalarda keçirənlərdə uzunmüddətli toxunulmazlıq olur
Yüngül və ya gizli halda (asimptomatik) koronavirus infeksiyası keçirənlərdə uzunmüddətli toxunulmazlıq yarandığı aşkarlanıb. e- -a istinadən bildirir ki, bu, İngiltərə alimlərinin (London Kraliça Mariya Universiteti) apardığ

Bunlar uşaqlarda D vitamini əskikliyi yarada bilər – Həkimdən valideynlərə pandemiya ilə bağlı TÖVSİYƏ
Uşaqlar hazırda pandemiya ilə əlaqədar olaraq bağça və məktəbə gedə bilmirlər. Dərslər onlayn keçirilir. Uşaqlar günün çox hissəsini evdə keçirmək məcburiyyətində qalırlar. Məktəbdə, bağçada olan uşaqların bir-biri ilə sosia

Koronavirusa yoluxub sağalanlara peyvənd lazımdırmı?
Bu gün koronavirus pandemiyası ilə bağlı ən çox aktual olan suallardan biri də virusa yoluxanların vaksinasiyası ilə bağlıdır. Virusa yoluxub sağalanlarda qoruyucu immunitetin yaranmasını əsas gətirərək peyvəndə gərək olmadığın

Pandemiya nə zaman bitəcək, koronavirus haçan təhlükəsiz olacaq?
Bu gün hər kəsi koronavirus pandemiyasının nə zaman başa çatacağı, virusun nə zaman təhlükə yaratmayacağı, insanların haçandan rahat yaşayağacı kimi suallar düşündürür. Bununla bağlı yekdil, birmənalı cavab yoxdur, mütəxəssislə

 8 mart – Beynəlxalq Qadınlar günü münasibətilə təbrik
8 mart – Beynəlxalq Qadınlar günü münasibətilə təbrik Yuxuda sevdiyin insanı görmək
Yuxuda sevdiyin insanı görmək Kişiləri ehtiraslandıran sözlər
Kişiləri ehtiraslandıran sözlər İdeal Dieta: 1 həftəyə 5 kq arıqla!
İdeal Dieta: 1 həftəyə 5 kq arıqla! Qara zirə (Çörək otunun) faydaları
Qara zirə (Çörək otunun) faydaları Qarazirə hər dərdin çarəsi olan bitki
Qarazirə hər dərdin çarəsi olan bitki Ən güclü təbii antibiotik: Udi hindi bitkisinin faydaları
Ən güclü təbii antibiotik: Udi hindi bitkisinin faydaları Öd kisəsi ağrıyanda nə etməli? - 5 MƏSLƏHƏT
Öd kisəsi ağrıyanda nə etməli? - 5 MƏSLƏHƏT Bir kasası xəstəliyi qapıdan qovur: Şəfa mənbəyidir
Bir kasası xəstəliyi qapıdan qovur: Şəfa mənbəyidir Dirilik suyu – Şalğam: Min dərdə dəva olan sehirli içkinin əvəzsiz faydaları
Dirilik suyu – Şalğam: Min dərdə dəva olan sehirli içkinin əvəzsiz faydaları Bu torpaqlarda yetişir: Təpədən-dırnağa antibiotik anbarı çıxdı
Bu torpaqlarda yetişir: Təpədən-dırnağa antibiotik anbarı çıxdı Çərəz yeyərkən "tək bir şərt" var
Çərəz yeyərkən "tək bir şərt" var Röya Aygünün mahnısını oxuyacaq
Röya Aygünün mahnısını oxuyacaq Mənim daşım yaman ağırdır
Mənim daşım yaman ağırdır İsveçli müğənni Avroviziyanı boykot etdi
İsveçli müğənni Avroviziyanı boykot etdi